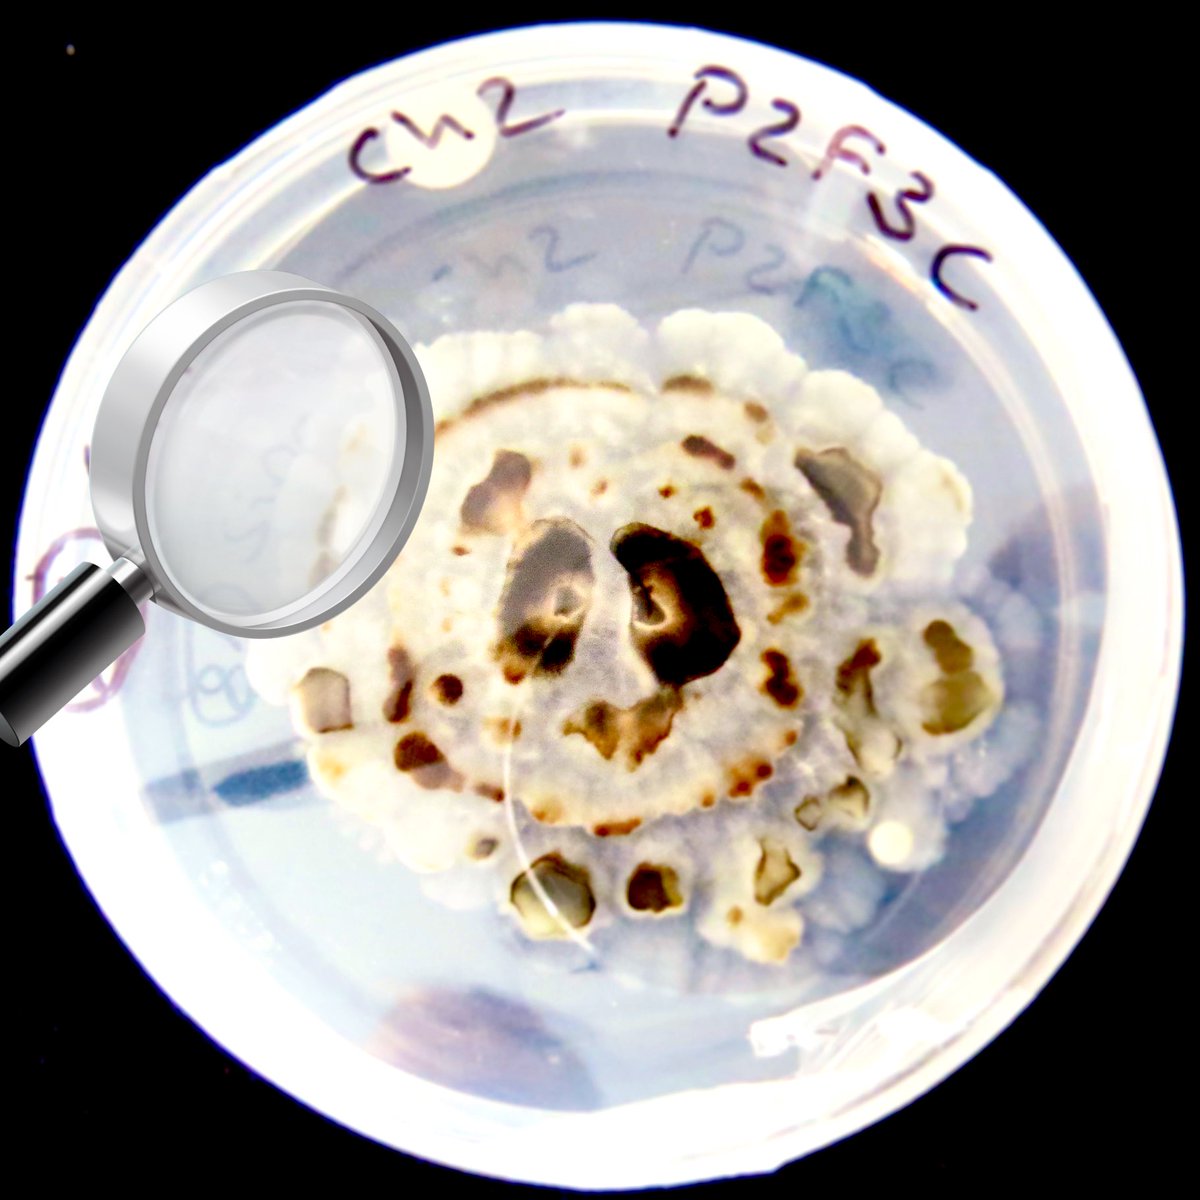
Dr. Banana (Ph.D) 🍌 tweet media

Sabitlenmiş Tweet

Still processing yesterday's events, but thanks to everyone celebrating with me!🍾I am so lucky to be part of such a great team, be surrounded by friends & to have such an amazing supervisor @DanSmale1 supporting me on my PhD journey! 🥰🎓 Apparently, I am Dr Nora Salland now 🤓
English